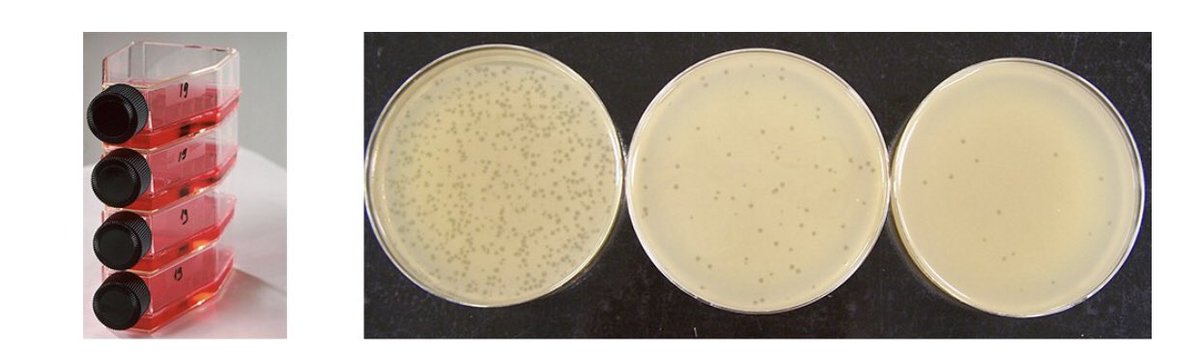

نعمل له تسلسل جيني Sequence لكي نعرف مكوناته وحجمه والجينات اللي فيه ولكي اقوم بهذه العملية احتاج ان يكون الفايروس في قمة ضراوته وفكرتها انك تكرر عملية الاستزراع وتسمى Serial Passage، الان انا لدي طريقتين لاستزراع الفايروس او تنميته الاولى داخل الخلايا وتسمى cell culture (٢)
ان يكون البيض معقم وراح اقسم البيض الى مجموعتين اذا بحقن فايروس واحد والى ثلاثة اذا عندي عترتينن مثلا من نفس الفايرس ( كل عترة في عضو يختلف عن الثاني)، الفكرة فيه مجموعة كنترول المفروض الجنين ينمو فيها طبيعي لما يجي وقت فتح البيض، واقارن بالتغيرات المرضية التي حدثت للجنين(٥)
جاري تحميل الاقتراحات...